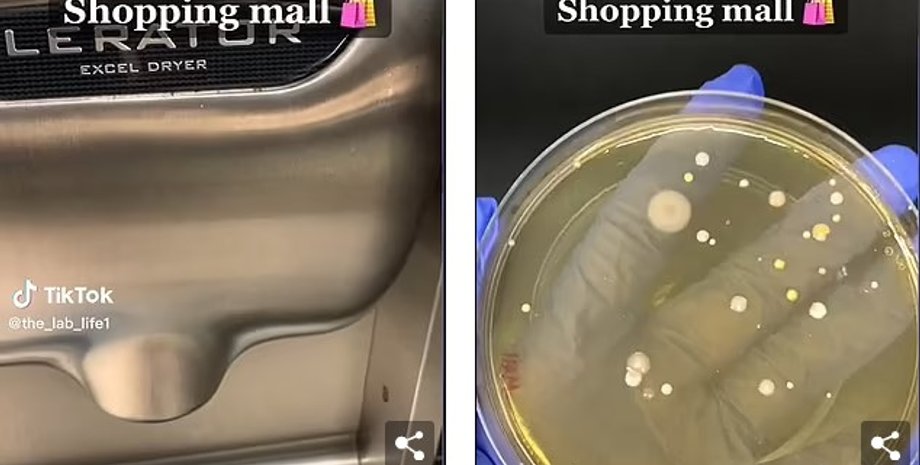
микробы в туалете, образцы
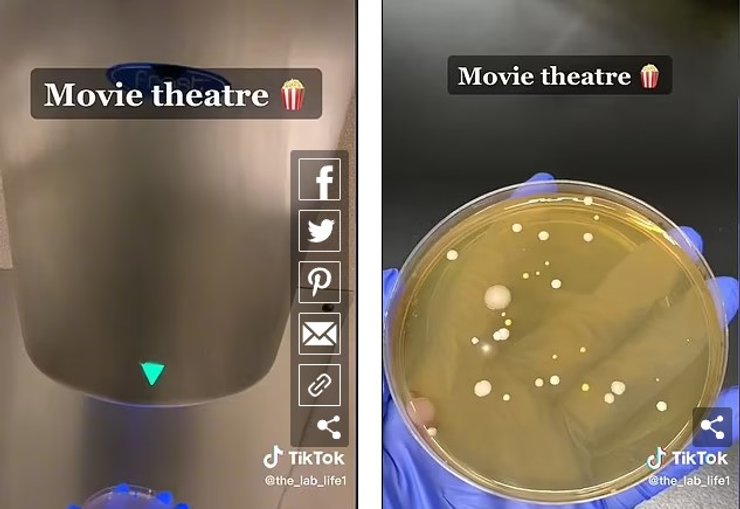
образцы театр
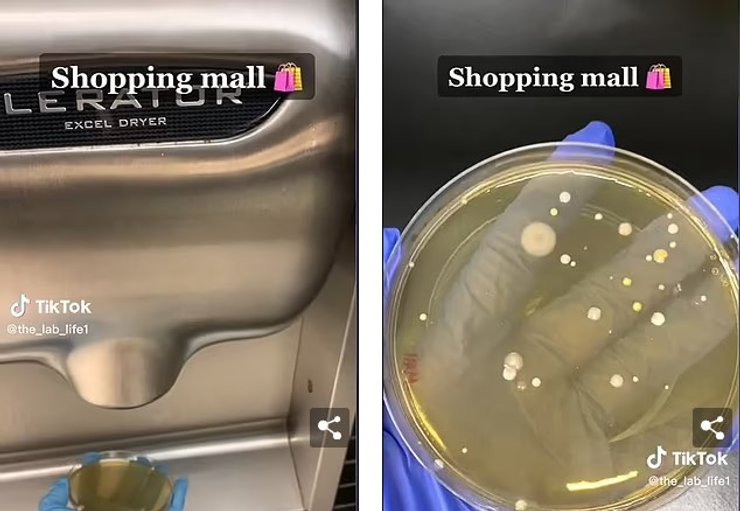
образцы торговый центр

Выдувают фекальные облака и туман микробов. Чем опасны сушилки для рук в общественном туалете (видео)
Ученые провели эксперимент, чтобы понять, какие микробы и бактерии выдувают сушилки на наши только что вымытые руки — результаты отвратительны.
Общественные туалеты скрывают множество грязных секретов: начиная от микробов и бактерий, витающих в воздухе и заканчивая сушилками для рук, которые поглощают весь этот "отвратительный коктейль" из воздуха и выдувают на наши только что вымытые руки, пишет Daily Mail.
В ходе исследования ученый собрал образцы из общественных туалетов в торговом центре, кинотеатре и на своей работе — все образцы были помещены в чашки Петри. После инкубации образцов оказалось, что все три содержат липкие, пузырящиеся организмы.
У Фокус. Технологии появился свой Telegram-канал. Подписывайтесь, чтобы не пропускать самые свежие и захватывающие новости из мира науки!
Ученые отмечают, что причина не в том, что сами сушилки для рук пронизаны бактериями. Основная проблема заключается в том, что они захватывают воздух из общественных туалетов, которые буквально кишат фекальными облаками и туманом микробов. И все это в конечном итоге, оседает на ваших только что вымытых руках.
Отметим, что ученые не стали уточнять какие именно бактерии они обнаружили в образцах, однако более ранние исследования свидетельствуют о том, что в общественных туалетах скрываются кишечная палочка, гепатит и фекальные бактерии.
Ученая под ником @the_lab_life1 разместила результаты своего эксперимента в TikTok — в общей сложности видео уже набрало более 12 миллионов просмотров, а судя по комментариям — пользователи весьма шокированы такой правдой.
В ходе эксперимента ученые также взяли один из образцов в ванной комнате. Отметим, что он стал единственным, не пронизанным бактериями. Известно, что более ранние исследования также показали, что в общественных туалетах могут скрываться такие опасности как:
- грипп;
- стрептококк;
- метициллин-резистентный золотистый стафилококк;
- сальмонелла;
- шигелла;
- норовирус.
Исследование 2015 года показывает, что в общественных туалетах обитают порядка 77 тысяч различных микробов. А когда здесь используется мощная сушилка для рук, все эти микробы буквально поднимаются с поверхностей и распыляются на наши руки.
Исследователи обнаружили, что образцам из общественных туалетов без сушилок для рук потребовалось 18 часов, чтобы образовались 6 колоний патогенов. Однако образцам из общественных туалетов с сушилками потребовалось всего 30 секунд, чтобы выросло более 250 колоний.
Исследователи отмечают, что большая часть бактерий в воздухе возникает из-за смыва туалетов, в результате по всему помещению распыляется тонкий слой микробов, в том числе и фекальных облаков. Для примера, на близком расстоянии от струйной воздушной сушилки исследователи обнаружили 59,5 колоний дрожжей по сравнению со средним показателем всего 2,2 колонии для бумажных полотенец. Именно поэтому исследователи призывают по возможности использовать бумажные полотенца и не прикасаться к сушилкам для рук.
Ранее Фокус писал о том, что ученые рассказали всю неприятную правду о купании в джакузи.